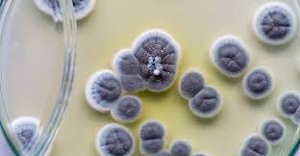
Penicillium colonies on agar

BackEukaryotic Microorganisms: Diversity, Structure, and Examples
Study Guide - Smart Notes
Tailored notes based on your materials, expanded with key definitions, examples, and context.
Eukaryotic Microorganisms
Introduction to Microbial Diversity
Microorganisms are classified into three domains: Bacteria, Archaea, and Eukarya. Eukaryotic microorganisms include fungi, protozoa, algae, and helminths. Understanding their classification, structure, and function is essential for microbiology students.
Three Domains of Life
Bacteria, Archaea, and Eukarya
Bacteria and Archaea are prokaryotic, lacking a true nucleus and membrane-bound organelles.
Eukarya includes all eukaryotic organisms, which possess a true nucleus and organelles.


Eukarya Supergroups
Major Supergroups and Their Characteristics
Unikonta: Includes heterotrophs such as amoebas, animals, and fungi. Characterized by early evolutionary divergence from other eukaryotes. Many have a cyst (resting) and trophozoite (feeding) stage.
Archaeplastida: Descended from an ancestor that engulfed a cyanobacterium, leading to the evolution of chloroplasts in green algae, red algae, and plants. These organisms are autotrophic.
SAR: Composed of alveolates, rhizarians, and stramenopiles. Originated from a heterotroph engulfing a red alga. Some members possess cilia for movement.
Excavata: Unicellular species with a feeding groove and one or more flagella. Many have cyst and trophozoite stages.
Transition from Prokaryotic to Eukaryotic Microorganisms
Key Differences Between Prokaryotes and Eukaryotes
Prokaryotes: Bacteria and Archaea; lack a nucleus, have circular chromosomes, no organelles, 70S ribosomes, and divide by binary fission.
Eukaryotes: Fungi, protozoa, algae, helminths; have a true nucleus, linear chromosomes, organelles, 80S ribosomes, and divide by mitosis.
Fungi (Supergroup Unikonta)
General Characteristics
Fungi are eukaryotic organisms that include yeasts, molds, and mushrooms. They play important roles in decomposition, food production, and as pathogens.
Saccharomyces cerevisiae (Budding Yeast)
Single-celled eukaryote used in bread, beer, and wine production.
Candida albicans can cause yeast infections and oral thrush.

Aspergillus
Common mold found indoors and outdoors; spores are widespread in the air.
Rarely causes illness in healthy individuals but can be opportunistic in immunocompromised hosts.



Penicillium
Important mold in natural environments and biotechnology.
Some species produce the antibiotic penicillin; others are used in cheese production (e.g., Brie, Roquefort).

Rhizopus (Common Bread Mold)
Genus of saprophytic molds found on decaying organic matter such as bread, fruits, and vegetables.
Some species are opportunistic pathogens in humans and animals.





Protozoa
General Characteristics
Protozoa are single-celled eukaryotes that may be free-living or parasitic. They feed on organic matter and are found in diverse environments.
Family Amoebidae (Supergroup Unikonta)
Amoebas are unicellular, heterotrophic organisms capable of changing shape.
Common in soil and aquatic habitats; some are parasitic (e.g., brain-eating amoeba).
Phylum Ciliophora (SAR Supergroup): Paramecium
Paramecium uses cilia for locomotion and feeding.
Contains both macronuclei (for everyday function) and micronuclei (for reproduction).

Giardia lamblia (Excavata Supergroup)
Microscopic parasite causing giardiasis (Beaver Fever).
Has a cyst (resting) stage and a trophozoite (feeding) stage.


Trypanosoma gambiense (Excavata Supergroup)
Thin, crescent-shaped parasite causing African sleeping sickness (African trypanosomiasis).
Transmitted by tsetse flies in sub-Saharan Africa.


Euglena (Excavata Supergroup)
Unicellular, flagellated, photosynthetic organism.
Can switch between autotrophic and heterotrophic nutrition depending on environmental conditions.
Summary Table: Key Differences Between Prokaryotes and Eukaryotes
Feature | Prokaryotes | Eukaryotes | |
|---|---|---|---|
Domains | Bacteria, Archaea | Eukarya (Fungi, Protozoa, Algae, Helminths) | |
Nucleus | Absent | Present | |
Chromosomes | One, circular | Several, linear | |
Histones | No | Yes | |
Ribosomes | 70S | 80S | |
Organelles | Absent | Present | |
Cell Wall | Peptidoglycan (most) | Polysaccharide (if present) | |
Division | Binary fission | Mitosis |